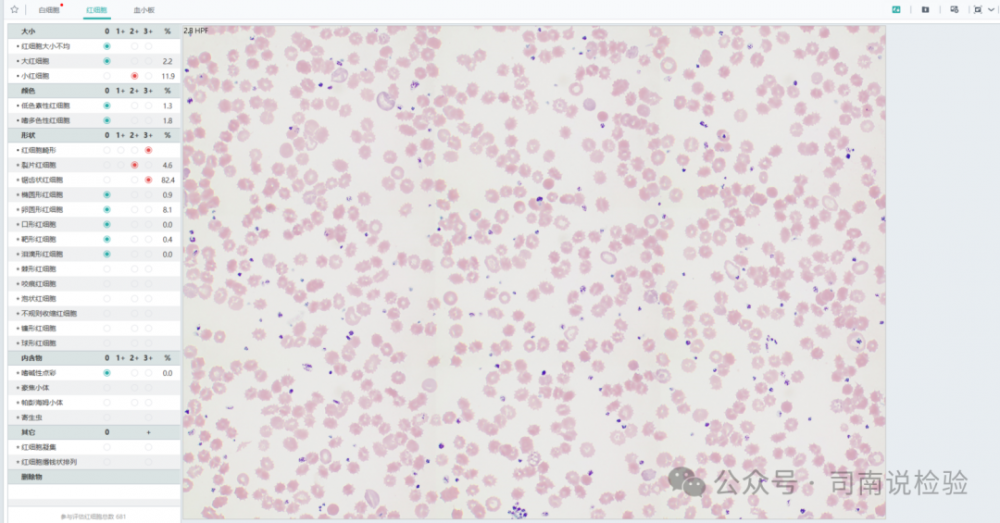

你问我答098:血常规标本放了三天了,还能用吗?
写在前面:
今天遇到的问题:老师,我这个血常规三天前采样的,还能用吗?今天就说说这个问题,看看是不是你想要的答案。

01血常规运输、存储、检查的时间都是多久?
★在临床检验样本转运及保存规范化专家共识2023:提到关于血常规、血型、血沉等运输时限要求为小于8小时,冷藏为小于24小时,疟原虫小于1小时,标本保存时间为冷藏1-7天,血涂片2周,血型为1个月。
★WS/T 806-2022临床血液与体液检验基本技术标准:血细胞分析的临床标本宜在采集后 8 h 内完成检测。进行疟原虫检查的静脉血标本在采集后 1 h 内同时制备厚片和薄片。如未能在采血后 1 h 内制片,需在报告中标注。
★实验室中的标本基本上早上来的比较多,且异常标本比较集中,临床实践中,血常规上的TAT基本上都是30min到60min(特殊标本除外),因此,3天的标本就不建议进行检测了(特殊标本除外)。
02标本放置时间长会对检验结果的影响
★有研究表明:在室温(25℃),超过4小时后,MCV和MCHC会因血液标本存储时间的增加而升高,可能是因血细胞处于高渗状态导致渗透压增加;在血液与低渗稀释液混合后红细胞水分会流失,导致MCV增加,而红细胞体积增高后,红细胞平均血红蛋白浓度也会随之增加。室温放置24小时对血小板影响最大,血小板具有不稳定性,容易受保存时间和保存温度的影响,可能是血小板本身具有凝聚特征,形成较大的颗粒,在灵敏的自动化血液分析仪中只能鉴别出细胞大小,忽略了细胞的性质,导致血小板在不同保存时间和温度下差异较大。
★有研究表明, 室温保持20~25℃状态下, 标本放置在6h内对于血常检测白细胞、红细胞、血小板和血色素水平并无显著改变。但随时间延长,PLT(血小板)有增长趋势,而且比其他指标更早出现明显变化,这种变化可能与血小板的形态变化特征等因素有关。MPV的变化可能与PLT与容器接触后释放化学物质,发生黏附聚集等变化,且由于溶质中渗透压的增加使PLT体积变大,引起 MPV检测结果升高。而血小板聚合体产物被计入白细胞计数范围,导致WBC计数呈现逐步上升趋势。
★对于形态学而言,陈旧标本的血涂片细胞容易出现皱缩或假球形,假剌形或空泡变性,颗粒脱落以及细胞肿胀破裂等异形性改变。因此,根据《中华人民共和国卫生行业标准》中的要求,细胞形态学检查应在标本采集后4小时内完成涂片。
03直观看一下保存时间对血常规结果的影响
(仅仅是一个测试)
★不同天数的实验室结果的影响
▼冷藏条件下,抹去单位:

▼室温条件下,抹去单位:

▼看其变化,可见数值上还是有变化的。
★看一看形态的改变(以中性粒细胞为主,冷藏保存)
▼第一天:

▼第二天:

▼第三天:

▼第四天:

★再看一看另外一个形态的改变(室温保存4天)
▼中性粒细胞:出现形态明显改变,细胞形态多样,空泡明显增多。

▼淋巴细胞:细胞出现花瓣样核

▼红细胞:细胞形态有显著变化,形态上出现大量皱缩红细胞
▼血小板:体积变大,形态上不完整 ,且发生聚集

▼涂抹细胞:出现大量的涂抹细胞

司南说:血常规标本当天送当天出结果(<8H),血涂片形态学检查4H内完成,对于长时间未送到实验室的标本根据科室规定进行处理(个人建议拒收),不多说了,最后还是那句话,对于检验而言细节决定成败,检以求真,验以正德!
说明:由于笔者知识储备有限、经验有限,本文主要是整理以往的资料与实际应用中的经验,仅供交流、学习与分享使用,原版版权归原作者所用,内容不作为临床诊疗依据,如有错误请私信笔者,非商业用途,仅供专业人士参考与交流,如有侵权请与笔者联系进行删除操作,谢谢!
参考文献:
1.尚红主编.全国临床检验操作操作规范(第四版)
2.诊断学第九版 人民卫生出版社
3.李军,刘东,傅奇. 血液标本放置时间对血常规检测结果的影响[
4.临床检验样本转运及保存规范化专家共识2023
5.WS/T 806-2022临床血液与体液检验基本技术标准
6.孔超,全血标本保存时间与温度对血常规结果的影响
7.高玉华,乐家新,王海红,兰亚婷,王红霞,血标本保存条件对自动血细胞分析仪检测结果的影响
8.李军,刘东,傅奇. 血液标本放置时间对血常规检测结果的影响
内容来源 | 司南说检验
图片来源 | veer、ibaotu
排版 | znm
审校 | 金宝

